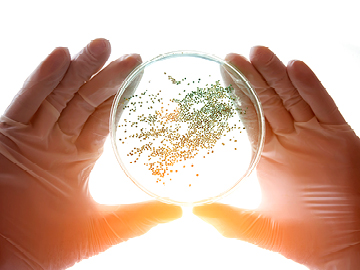

Søke
Søke >>
Vann
KontaktEt sunt og godt vannmiljø er en forutsetning for god livskvalitet, og drikkevann regnes som vårt viktigste næringsmiddel.
Eurofins Environment Testing Norway AS analyserer alle typer vann for både kvalitet og miljøstatus. Typiske bruksområder for våre analyser er kontroll av drikkevann fra private og offentlige vannverk, prosess- og avløpsvann fra industri, samt overvåkning av naturlige vannforekomster.